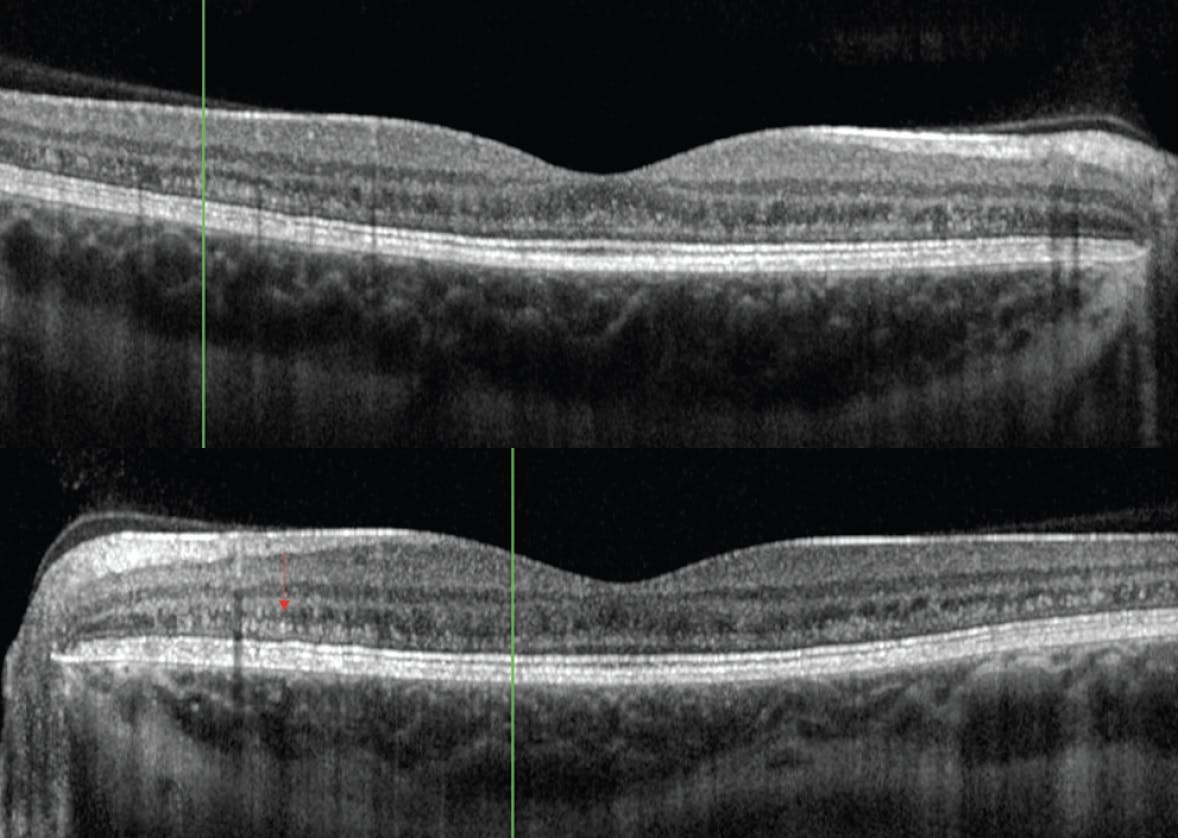

Everyone loves a good mystery, and retina specialists are no different. That rare “what is going on here” moment might shake up the clinical routine a bit, but it also helps hone your diagnostic skills. The mystery cases presented here are designed to help you stay on your toes and prepare for the next patient who presents with unexplained retinal findings.
- Rebecca Hepp, Editor-in-Chief
MYSTERY CASE NO. 1
By Scott R. Shuldiner, MD, and Nimesh A. Patel MD


A young adult woman was referred in the setting of abnormal retinal findings, although she was asymptomatic. Her last eye examination had been 10 years prior. On initial examination, her BCVA was 20/20 OD and 20/30 OS. Her dilated fundus examination was significant for 360° peripheral retinal hyperpigmentation (Figure 1). OCT imaging revealed outer plexiform deposits in the macula of each eye (Figure 2). Fundus autofluorescence (FAF) showed hypofluorescence in areas of atrophy in the periphery and punctate areas of hyperfluorescence in the areas of the deposits (Figure 3). Visual fields were full bilaterally.

Figure 1. The fundus examination revealed 360° peripheral retinal hyperpigmentation in the right (A) and left eye (B).
Figure 2. OCT imaging was remarkable for outer plexiform deposits (red arrow) in the macula of each eye.

Figure 3. In the right (A) and left (B) eye, FAF showed hypofluorescence in the areas of atrophy and punctate areas of hyperfluorescence in the area of the deposits.
During a detailed review of systems, the patient endorsed mild but progressive exertional chest pain for the last 3 months. A cardiology referral was initiated, where an echocardiogram demonstrated severe symmetric hypertrophic cardiomyopathy.
MYSTERY CASE NO. 2
By Sayena Jabbehdari, MD, MPH, and Sami H. Uwaydat, MD


A 37-year-old White man presented for evaluation of progressive worsening of vision over several years. The patient reported seeing wavy lines and occasional blurring of letters. He also complained of floaters in each eye. His past medical history included diabetes, hypertrophic cardiomyopathy, skeletal myopathy/exercise intolerance, deafness, and depression. His past social history was unremarkable.
On examination, his BCVA was 20/50 OD and 20/25 OS. IOP was normal, and the anterior segments were unremarkable. Fundus examination revealed pigmentary changes in the macula along the arcades in each eye. OCT revealed focal loss of outer retinal layers in each eye (Figure 4).

Figure 4. Fundus photography showed pigmentary changes in the macula and along the arcades of each eye. FAF shows a curvilinear hyperfluorescent area around the macula surrounded by an indistinct hypofluorescent pattern in each eye. OCT reveals focal loss of outer retinal layers in each eye.
MYSTERY CASE NO. 3
By Luís Bernardes, MD, and João Pedro Marques, MD, PhD


A 57-year-old woman was referred for diabetic retinopathy (DR) screening. She had been diagnosed with diabetes at age 30, and her last ophthalmic observation was 3 years prior after undergoing cataract surgery in the left eye. Her history was positive for arterial hypertension and hearing loss. The patient said that her mother had hearing difficulties and low vision, presumably due to cataract.
The fundus examination revealed bilateral peripapillary atrophy along with patchy areas of chorioretinal atrophy (Figure 5A and 5B). A high degree of inter-eye symmetry was noted. FAF showed macular speckled hyper- and hypoautofluorescence (Figure 5C and 5D). This was also noted on near-infrared reflectance (Figure 5E and 5F); on OCT, atrophy of the outer retinal layers and retinal pigment epithelium (RPE) was present in the topographical location of the patchy atrophic lesions (Figure 5G and 5H).

Figure 5. Fundus imaging showed bilateral peripapillary atrophy along with patchy areas of chorioretinal atrophy in the posterior pole, sparing the fovea (A and B). FAF showed macular speckled hyper- and hypoautofluorescence, outlining the patchy atrophy (C and D). This was also noted on near-infrared reflectance (E and F). OCT showed atrophy of the outer retinal layers and RPE in the topographical location of the patchy atrophic lesions (G and H).
DISCUSSION
Case No. 1: Danon Disease
Genetic testing was positive for an X-linked pathogenic variant in the lysosome-associated membrane protein-2 (LAMP2) gene (c864+1G>T, Intron 6). Based on the patient’s genetic mutation and history of hypertrophic cardiomyopathy, she was diagnosed with retinal dystrophy in the setting of Danon disease.
Danon disease is a rare X-linked lysosomal glycogen storage disease with the classic triad of cardiomyopathy, myopathy, and variable intellectual disability. In the absence of treatment, patients experience supraventricular arrhythmias and are at risk for sudden death before the age of 30; defibrillators and heart transplantation have significantly improved life expectancy.1 LAMP2, a glycoprotein that plays a critical role in lysosomal biogenesis and phagosome maturation, is part of a growing number of genes associated with retinopathy. The phenotype of Danon disease may also include a diffuse cone-rod dystrophy and other maculopathies.2 Ophthalmic manifestations are common and may affect a variety of structures with signs including corneal clouding, optic atrophy, glaucoma, retinal degeneration, and decreased electroretinogram wave amplitude.3,4 Recent studies suggest that patients with Danon disease show progressive and diffuse retinal and macular degeneration changes, including pigmentary disturbances and discrete sub-RPE deposits.5 The long-term prognosis for carriers of LAMP2 mutations is not known, and there is a need for serial retinal examinations and electrophysiology testing to monitor for progression.6
Our patient continues to be monitored for progression. Since this time, a pacemaker and implantable cardioverter-defibrillator have been placed to prevent arrhythmias.
Case No. 2: MELAS
Genetic testing revealed a pathogenic mutation in the mt-TL1 gene (m.3243A>G) with a heteroplasmy of 55.5%. This genetic mutation is classically associated with mitochondrial encephalopathy, lactic acidosis, strokes/stroke-like episodes (MELAS) syndrome, and maternally inherited diabetes and deafness (MIDD).7,8
MELAS syndrome is a maternally inherited condition that impairs the oxidative phosphorylation/ATP production.7 Patients usually present with seizures, short stature, stroke-like episodes, lactic acidosis, deafness, episodic vomiting, and proximal muscle weakness before the age of 40.9,10 The common ocular manifestations of MELAS include ptosis, ophthalmoplegia, myopia, retinal pigment mottling, chorioretinal atrophy, nuclear cataract, and optic atrophy due to the high metabolic activities in the affected mitochondria.11 Pigmentary retinopathy involving mainly the posterior pole and midperiphery of the retina is the most common ocular manifestation of MELAS. However, the retinopathy can range from mild “salt and pepper” retinopathy to severe bone spicules with RPE atrophy.12 The histologic changes include depigmentation and hyperpigmentation of the RPE, photoreceptor degeneration, ganglion cell loss, and degeneration of the choroid.13-15
Our patient was unable to tolerate the prescribed mitochondrial oral cocktail (L-carnitine, co-enzyme Q, thiamine, riboflavin, nicotinamide, biotin, and L-creatine); at the last follow-up, his BCVA had decreased to 20/60 OD and 20/40 OS.
Case No. 3: MIDD
Given the clinical picture and imaging findings, the patient underwent mitochondrial DNA sequencing. The m.3243A>G variant on the mt-TL1 gene was found in heteroplasmy, confirming a diagnosis of MIDD. After 2 years of follow-up, no significant progression of the atrophic lesions was observed, and the patient remains asymptomatic.
MIDD has an estimated prevalence of 1 to 9 in 1,000,000 individuals.7 The hallmarks of disease include early-onset insulin-dependent diabetes/impaired fasting glucose, progressive sensorineural hearing impairment (usually preceding the onset of diabetes), maculopathy, and a normal/low body mass index.16-18 Additionally, patients with MIDD may have short stature, proximal limb myopathy, left ventricular hypertrophy, renal failure, and gastrointestinal disease.7 Interestingly, DR is considerably less common than that in other forms of diabetes.16
Most affected individuals harbor the m.3243A>G mutation in the mt-TL1 gene, the single most common pathogenic mitochondrial variant.19 Because mutations occur in the mitochondrial DNA, maternal inheritance is observed.17 However, no clear correlation exists between mutational load (heteroplasmy) and phenotypic expression/severity.18
Most patients are asymptomatic and diagnosed based on clinical findings, such as pattern dystrophy-like changes and slowly progressive patchy atrophy of the RPE, localized at the posterior pole and frequently involving the peripapillary area.16,17,20 The fovea is often preserved, thus conferring a favorable functional prognosis to most patients. No proven intervention is available for MIDD-associated maculopathy, but regular screening for traditional diabetes-related microvascular complications is advisable. Early coenzime Q10 supplementation has shown promise in preventing hearing loss and delaying progression in diabetes.21
1. Sugie K, Yamamoto A, Murayama K, et al. Clinicopathological features of genetically confirmed Danon disease. Neurology. 2002;58(12):1773-1778.
2. Schorderet DF, Cottet S, Lobrinus JA, Borruat FX, Balmer A, Munier FL. Retinopathy in Danon disease. Arch Ophthalmol. 2007;125(2):231-236.
3. Biswas J, Nandi K, Sridharan S, Ranjan P. Ocular manifestation of storage diseases. Curr Opin Ophthalmol. 2008;19(6):507-511.
4. Notomi S, Ishihara K, Efstathiou NE, et al. Genetic LAMP2 deficiency accelerates the age-associated formation of basal laminar deposits in the retina. Proc Natl Acad Sci. 2019;116(47):23724-23734.
5. Thiadens AA, Slingerland NW, Florijn RJ, Visser GH, Riemslag FC, Klaver CC. Cone-rod dystrophy can be a manifestation of Danon disease. Graefes Arch Clin Exp Ophthalmol. 2012;250(5):769-774.
6. Prall FR, Drack A, Taylor M, et al. Ophthalmic manifestations of Danon disease. Ophthalmology. 2006;113(6):1010-1013.
7. Murphy R, Turnbull DM, Walker M, Hattersley AT. Clinical features, diagnosis and management of maternally inherited diabetes and deafness (MIDD) associated with the 3243A>G mitochondrial point mutation. Diabet Med. 2008;25(4):383-399.
8. Bryan JM, Rojas CN, Mirza RG. Macular findings expedite accurate diagnosis of MIDD in a young female patient with newly diagnosed diabetes. Am J Ophthalmol Case Rep. 2022;27:101578.
9. de Laat P, Smeitink JAM, Janssen MCH, Keunen JEE, Boon CJ. Mitochondrial retinal dystrophy associated with the m.3243A>G mutation. Ophthalmology. 2013;120(12):2684-2696.
10. El-Hattab AW, Adesina AM, Jones J, Scaglia F. MELAS syndrome: clinical manifestations, pathogenesis, and treatment options. Mol Genet Metabol. 2015;116(1-2):4-12.
11. Jahrig C, Ku CA, Marra M, Pennesi ME, Yang P. Vitelliform maculopathy in MELAS syndrome. Am J Ophthalmol Case Rep. 2023;30:101842.
12. Kamal-Salah R, Baquero-Aranda I, Grana-Pérez Mdel M, García-Campos JM. Macular pattern dystrophy and homonymous hemianopia in MELAS syndrome. BMJ Case Rep. 2015;2015:bcr2014206499.
13. Jones M, Mitchell P, Wang JJ, et al. MELAS A3243G mitochondrial DNA mutation and age-related maculopathy. Am J Ophtalmol. 2004;138:1051-1053.
14. Romano F, Cozzi M, Staurenghi G, Salvetti AP. Multimodal retinal imaging of m.3243A>G associated retinopathy. Am J Ophthalmol Case Rep. 2022;26:101411.
15. Michaelides M, Jenkins SA, Bamiou DE, et al. Macular dystrophy associated with the A3243G mitochondrial DNA mutation. Distinct retinal and associated features, disease variability, and characterization of asymptomatic family members. Arch Ophthalmol. 2008;126(3):320-328.
16. Massin P, Virally-Monod M, Vialettes B, et al. Prevalence of macular pattern dystrophy in maternally inherited diabetes and deafness. GEDIAM Group. Ophthalmology. 1999;106(9):1821-1827.
17. Panchal B, Saoji K. Commentary: Heteroplasmy in maternally inherited diabetes and deafness. Indian J Ophthalmol. 2020;68(1):253.
18. Robinson KN, Terrazas S, Giordano-Mooga S, Xavier NA. The role of heteroplasmy in the diagnosis and management of maternally inherited diabetes and deafness. Endocr Pract. 2020;26(2):241-246.
19. Ferreira CR, van Karnebeek CDM, Vockley J, Blau N. A proposed nosology of inborn errors of metabolism. Genet Med. 2019;21(1):102-106.
20. Ovens CA, Ahmad K, Fraser CL. Fundus autofluorescence in maternally inherited diabetes and deafness: the gold standard for monitoring maculopathy? Neuroophthalmology. 2020;44(3):168-173.
21. Suzuki S, Hinokio Y, Ohtomo M, et al. The effects of coenzyme Q10 treatment on maternally inherited diabetes mellitus and deafness, and mitochondrial DNA 3243 (A to G) mutation. Diabetologia. 1998;41(5):584-588.























